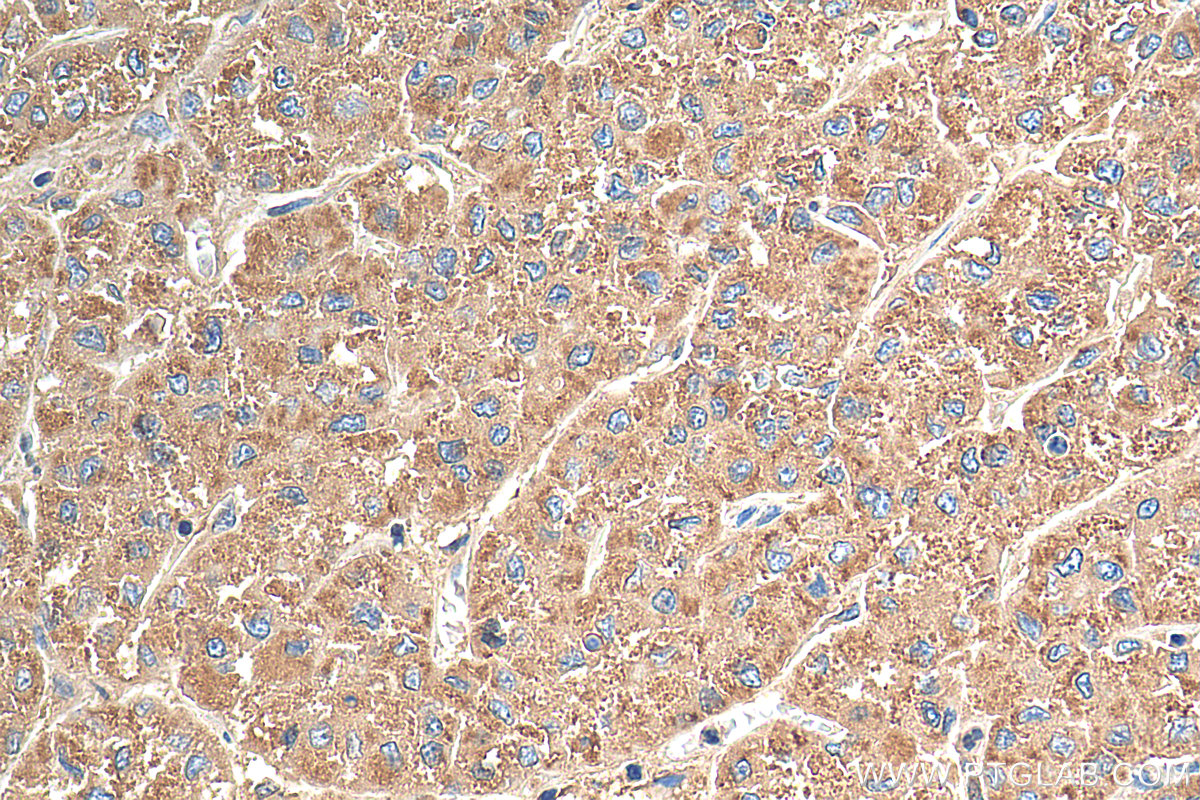

Various lysates were subjected to SDS PAGE followed by western blot with 66665-1-Ig (Beclin 1 antibody) at dilution of 1:10000 incubated at room temperature for 1.5 hours.
Untreated and chloroquine treated HEK-293 cells, untreated and chloroquine treated HeLa cells were subjected to SDS PAGE followed by western blot with 81004-1-RR (LC3 antibody) at dilution of 1:5000 incubated at room temperature for 1.5 hours.
arious lysates were subjected to SDS PAGE followed by western blot with 84826-1-RR (P62,SQSTM1 antibody) at dilution of 1:5000 incubated at room temperature for 1.5 hours.
Various lysates were subjected to SDS PAGE followed by western blot with 81803-1-RR (ATG5 antibody) at dilution of 1:10000 incubated at room temperature for 1.5 hours.
U-937 cells were subjected to SDS PAGE followed by western blot with 21997-1-AP (LAMP1 antibody at dilution of 1:2000 incubated at room temperature for 1.5 hours.
IP result of anti-P62,SQSTM1 (IP:84826-1-RR, 4ug; Detection:84826-1-RR 1:4000) with NIH/3T3 cells lysate 1920 ug.
IP result of anti-ATG5(IP:81803-1-RR, 4ug; Detection:81803-1-RR 1:2000) with HeLa cells lysate 1800 ug.
Immunohistochemical analysis of paraffin-embedded human stomach tissue slide using 66665-1-Ig (Beclin 1 antibody) at dilution of 1:500 (under 10x lens).
Immunohistochemical analysis of paraffin-embedded human colon cancer tissue slide using 81004-1-RR (LC3 antibody) at dilution of 1:500 (under 10x lens). Heat mediated antigen retrieval with Tris-EDTA buffer (pH 9.0).
Immunohistochemical analysis of paraffin-embedded mouse brain tissue slide using 84826-1-RR (P62,SQSTM1 antibody) at dilution of 1:400 (under 10x lens). Heat mediated antigen retrieval with Tris-EDTA buffer (pH 9.0).
Immunohistochemical analysis of paraffin-embedded human ovary tumor tissue slide using 81803-1-RR (ATG5 antibody) at dilution of 1:1000 (under 10x lens). Heat mediated antigen retrieval with Tris-EDTA buffer (pH 9.0).
Immunohistochemical analysis of paraffin-embedded human liver cancer tissue slide using 21997-1-AP (LAMP1 antibody) at dilution of 1:200 (under 40x lens). Heat mediated antigen retrieval with Tris-EDTA buffer (pH 9.0).
Immunofluorescent analysis of (4% PFA) fixed mouse heart tissue using 66665-1-Ig (Beclin 1 antibody) at dilution of 1:100 and Alexa Fluor 488-Conjugated AffiniPure Goat Anti-Mouse IgG(H+L).
Immunofluorescent analysis of (-20°C Methanol) fixed Chloroquine treated HeLa cells using LC3 antibody (81004-1-RR, Clone: 5P12 ) at dilution of 1:1000 and CoraLite®488-Conjugated AffiniPure Goat Anti-Rabbit IgG(H+L), CoraLite®594 Beta Actin antibody (CL594-66009, Clone: 2D4H5, red).
Immunofluorescent analysis of (4% PFA) fixed NIH/3T3 cells using P62,SQSTM1 antibody (84826-1-RR, Clone: 241992C4 ) at dilution of 1:500 and CoraLite®488-Conjugated Goat Anti-Rabbit IgG(H+L) (SA00013-2), CL594-Phalloidin (red).